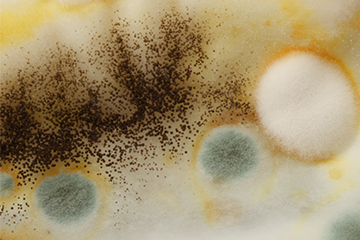

ALL COURSES
At OSHA COURSES PRO, we take pride in leading the industry in online training and certification, setting the standard for excellence in education across various sectors throughout the United States.
Filters
Price
Category

Reasonable Suspicion Training for Alcohol and Substance Abuse: DOT Requirements (U.S.)
$99.00 Original price was: $99.00.$59.00Current price is: $59.00.

Reasonable Suspicion Training for Alcohol and Substance Abuse in the Workplace (U.S.)
$99.00 Original price was: $99.00.$59.00Current price is: $59.00.

Powered Industrial Trucks – Operators Overview (French)
$59.99 Original price was: $59.99.$29.95Current price is: $29.95.

Load Securement and Distribution (US) (Spanish)
$59.99 Original price was: $59.99.$29.95Current price is: $29.95.

Healthy Buildings: Assessing Drinking Water (US)
$59.99 Original price was: $59.99.$29.95Current price is: $29.95.

Personal Protective Equipment (PPE): Electrical Protection
$59.99 Original price was: $59.99.$29.95Current price is: $29.95.

Personal Protective Equipment (PPE): Foot and Leg Protection
$59.99 Original price was: $59.99.$29.95Current price is: $29.95.

Personal Protective Equipment (PPE): Hand and Arm Protection
$59.99 Original price was: $59.99.$29.95Current price is: $29.95.

Personal Protective Equipment (PPE): Body Protection
$59.99 Original price was: $59.99.$29.95Current price is: $29.95.

Personal Protective Equipment (PPE): Respiratory Protection
$59.99 Original price was: $59.99.$29.95Current price is: $29.95.

Personal Protective Equipment (PPE): Eye and Face Protection
$59.99 Original price was: $59.99.$29.95Current price is: $29.95.

Personal Protective Equipment (PPE): Hearing Protection
$59.99 Original price was: $59.99.$29.95Current price is: $29.95.

Personal Protective Equipment (PPE): Head Protection
$59.99 Original price was: $59.99.$29.95Current price is: $29.95.

Personal Protective Equipment (PPE): Hazard Assessment
$59.99 Original price was: $59.99.$29.95Current price is: $29.95.
Healthy Buildings: Mold Awareness and Prevention
$59.99 Original price was: $59.99.$29.95Current price is: $29.95.

Fire Extinguishers: Classifications
$59.99 Original price was: $59.99.$29.95Current price is: $29.95.

